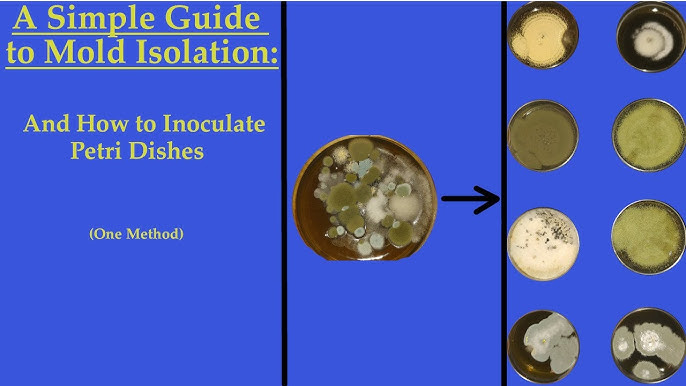
ice cream freezer bowl bacteria growth time lapse

You’ve just made the perfect batch of homemade ice cream, but now your Cuisinart freezer bowl is encased in frozen residue that seems welded to its curved interior. As you reach for the sink, you remember the critical warning: never use hot water. One wrong move could rupture the bowl’s double-insulated walls, leaking the special cooling liquid that makes your machine work. This isn’t just about convenience—it’s about protecting your $100 appliance and ensuring your next batch of mint chocolate chip doesn’t taste like last week’s strawberry sorbet. Learn the exact steps to clean your Cuisinart ice cream bowl in under 3 minutes while preserving its freezing efficiency for years.
Most users make the fatal mistake of letting the bowl thaw completely before cleaning. But that warm-up phase risks permanent damage to the cooling liquid sealed between the bowl’s walls. When that liquid warms beyond 100°F, it can expand and crack the insulation—a repair that costs more than a new bowl. Worse, lingering residue breeds bacteria and guarantees flavor contamination. Follow this guide immediately after churning to keep your machine performing like new, whether you’re making ice cream daily or storing it for next summer. You’ll master techniques that work with the bowl’s engineering—not against it—to transform dreaded cleanup into a seamless part of your dessert ritual.
Why Flavor Transfer Happens Within Minutes of Churning
Residual ice cream refreezes into flavor bombs that sabotage future batches the moment you add new ingredients. That speck of chocolate hiding in the bowl’s rim will turn your delicate vanilla into muddy swirls. More urgently, bacteria multiply exponentially when dairy sits above 40°F—meaning your “I’ll clean it later” plan creates a food safety hazard before you’ve even served dessert. The cooling liquid inside your bowl’s double walls stays vulnerable for exactly 120 seconds after churning stops. Beyond this window, partial thawing begins weakening the insulation’s integrity.
The 2-Minute Disassembly Deadline
Remove the freezer bowl from the motor base within 30 seconds of stopping the machine. Delaying lets ice form a vacuum seal between bowl and base that requires dangerous prying to break. Unplug the unit immediately, then twist the bowl counterclockwise while supporting the motor housing. If resistance occurs, tap the bowl’s rim gently with a rubber mallet—never strike metal parts. Once detached, separate the three components: bowl, paddle, and lid. Never let these sit together; trapped moisture creates hidden ice dams that complicate deep cleaning later.
Safe Scraping: Your First Defense Against Scratches
Use only the plastic spatula included with your Cuisinart—never metal or sharp tools. Angle the spatula at 30 degrees to the bowl surface and scrape in slow, overlapping circles starting from the center. Apply feather-light pressure; the goal is removing 90% of residue before water contact. If ice resists, let the bowl warm exactly 90 seconds at room temperature—no more. Longer exposure risks warming the cooling liquid past its safe threshold. Stop scraping the moment you feel the spatula glide smoothly; lingering creates microscopic grooves where bacteria hide.
Cold Water Rinse: The 60-Second Daily Method
This technique works because moving water melts residue without heat transfer. Hold the bowl under cold running tap water at a 45-degree angle, rotating slowly to cover all surfaces. Keep water pressure low—strong streams force liquid into the bowl’s vulnerable seam where walls meet. Work continuously for no longer than 60 seconds; timing is critical because even cold water warms the cooling liquid if left stagnant. Watch for cloudy water signaling dissolved residue; clear flow means you’re done. Any lingering streaks need the salt method below—don’t prolong rinsing.
Drying Protocol to Prevent Ice Crystals
Skip air drying—this causes refreezing disasters. Grab two lint-free microfiber towels: one for initial moisture absorption, the second for final polishing. Wipe the interior in tight spirals from center to rim, then invert the bowl onto a dry towel for 90 seconds to drain hidden water from the base. Check for shine on the surface—any wet spots will freeze into performance-killing crystals. Return the bowl to the freezer within 3 minutes of drying; delays force you to restart the 16-24 hour freezing cycle. Pro tip: Store a dedicated freezer towel inside your appliance’s storage bin for instant access.
Salt Technique for Rock-Hard Ice Buildup
Table salt melts ice through freezing point depression—not heat—making it safe for the cooling liquid. Sprinkle exactly 1 teaspoon of fine salt directly onto stubborn patches (coarse salt won’t dissolve fast enough). Wait 30 seconds while the salt creates a brine that liquefies ice from within. Never rub aggressively; use a damp cloth in gentle circular motions to lift residue. Rinse immediately under cold water for 10 seconds to remove all salt traces—leftover particles alter freezing chemistry and create icy patches in your next batch.
Alcohol Method for Emergency Ice Removal
When salt fails, food-grade ethanol (vodka) is your last resort. Pour 1 tablespoon onto frozen spots and wait 15 seconds; alcohol’s low freezing point dissolves ice without warming the bowl. Wipe instantly with a damp cloth—ethanol evaporates too fast for prolonged action. Rinse for 20 seconds under cold water to eliminate flavor contamination risks. Never use isopropyl alcohol; it leaves toxic residues even after rinsing. Reserve this for severe cases only, as repeated use degrades the bowl’s surface over time.
Deep Cleaning Process for Sanitized Performance

Lukewarm water (95°F max) is the only safe temperature for soaking. Fill the bowl with water just warm enough to feel neutral on your wrist, adding two drops of mild dish soap. Soak for exactly 10 minutes—set a timer. Longer exposure risks warming the cooling liquid beyond 100°F, causing irreversible damage. Use a soft sponge to clean the rim crevice where residue hides, inserting a toothpick for stubborn spots. Never twist the sponge aggressively; circular motions prevent micro-scratches that trap bacteria.
The Two-Towel Drying System
Air drying takes 30+ minutes—far too long for safe refreezing. After the final rinse, press one towel against the bowl’s interior to absorb 80% of moisture. Flip the bowl and press the second towel along the outer seam where water pools. Invert onto a dry surface for 2 minutes, then hand-dry the exterior. Verify complete dryness by rubbing a white paper towel inside—it should emerge spotless. Any dampness left will form ice crystals that reduce freezing efficiency by up to 40%.
Cleaning Paddle, Lid, and Motor Base Safely
The paddle and lid are dishwasher-safe—but only on the top rack. Place them vertically to avoid water pooling in crevices. For hand washing, use warm soapy water and a soft sponge for 60 seconds max. Inspect the paddle’s center hole for cracks after drying; hairline fractures cause uneven churning and bacterial growth. Never submerge the motor base—water contact destroys electrical components permanently. Instead, unplug it, then wipe with a cloth barely dampened with vinegar solution. Dry immediately with a second cloth, ensuring no moisture enters the drive shaft opening.
Motor Base Ice Buildup Emergency Fix
If ice forms around the drive mechanism, never chip it with tools. Unplug the unit, then wrap a bag of frozen peas in a towel and hold it against the base for 90 seconds. The cold retracts the ice just enough to twist the bowl free. Wipe residue with a vinegar-dampened cloth, then dry thoroughly. Test the motor by hand-spinning the drive shaft—it should rotate smoothly. If resistance occurs, delay use until completely dry to prevent electrical shorts.
Top 3 Mistakes That Destroy Cuisinart Bowls
Hot water is public enemy number one—even 110°F water can rupture the double walls within 2 minutes. Users who rinse with warm water report visible bubbles forming between the bowl’s layers, signaling cooling liquid leakage. Metal scrubbers create permanent scratches that harbor bacteria and create uneven freezing surfaces. Finally, leaving wet bowls on counters seems harmless but allows condensation that freezes into performance-killing crystals. Each mistake forces premature replacement, costing $50–$120.
Odor Removal Without Chemical Damage
Baking soda paste eliminates smells without harming insulation. Mix 1 tablespoon baking soda with 1 teaspoon water to form a spreadable paste. Apply inside the bowl, wait 5 minutes, then rinse under cold water for 30 seconds. For stubborn stains like berry residue, use equal parts vinegar and water—soak for 4 minutes max, then scrub gently with a soft brush. Never use bleach or abrasive cleaners; they degrade the bowl’s surface over time. Always finish with a cold water rinse to neutralize pH levels.
Storage System for Instant Freeze-Ready Bowls
Store the bowl upside down in the freezer to prevent condensation from forming ice crystals on the interior surface. Place it on a dedicated towel inside a reusable silicone bag—this catches any accidental drips during transfer. Mark cleaning dates with freezer-safe tape on the bag; bowls cleaned more than 30 days ago need a deep clean before reuse. During summer, pre-chill your cleaning water in the freezer for 10 minutes to minimize temperature shock during rinsing.
Performance Checklist Before Next Use
Shake the bowl vigorously—you should hear no liquid sloshing. Visible movement means the cooling liquid isn’t fully frozen, leading to soft-serve results. Inspect the interior under bright light for any haze or residue; even invisible traces cause flavor transfer. Test paddle rotation by hand—it must spin freely without wobble. If any step fails, restart the 16-24 hour freezing cycle. Never skip this check; compromised bowls ruin batches and waste expensive ingredients.
3-Minute Cleaning Schedule for Daily Users
After every batch: Scrape → cold rinse → two-towel dry → refreeze (3 minutes total). Weekly: Deep clean with baking soda paste for odor control (8 minutes). Monthly: Inspect paddle for cracks and wipe motor base exterior. Before seasonal storage: Complete deep clean, verify 100% dryness, and store upside down in a sealed bag.
Pro tip: Keep a second freezer bowl on hand. While one batch churns, the clean bowl refreezes for next-time use—eliminating 24-hour waits. This doubles your ice cream output and ensures immediate cleanup after each use. With these precise steps, your Cuisinart will deliver perfect texture for years, turning cleanup from a chore into your secret weapon for flawless frozen desserts.





